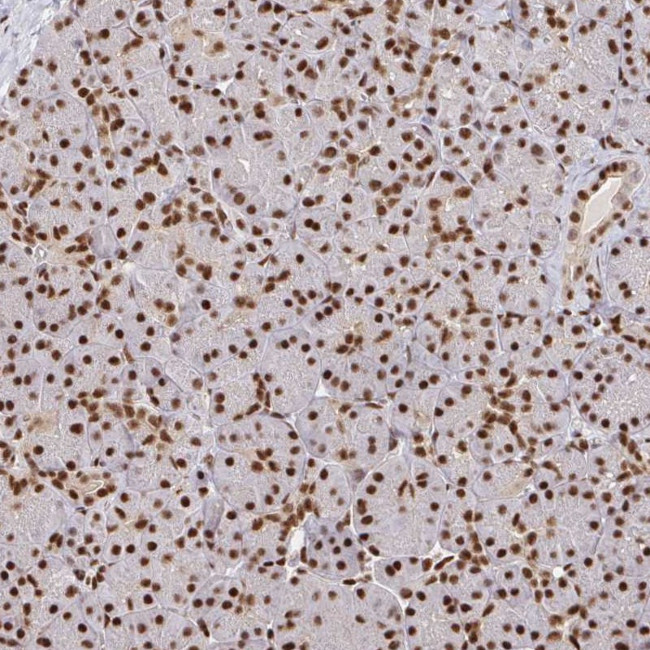
SP3 Antibody in Immunohistochemistry (Paraffin) (IHC (P))

Search
Invitrogen
SP3 Polyclonal Antibody
{{$productOrderCtrl.translations['antibody.pdp.commerceCard.promotion.promotions']}}
{{$productOrderCtrl.translations['antibody.pdp.commerceCard.promotion.viewpromo']}}
{{$productOrderCtrl.translations['antibody.pdp.commerceCard.promotion.promocode']}}: {{promo.promoCode}} {{promo.promoTitle}} {{promo.promoDescription}}. {{$productOrderCtrl.translations['antibody.pdp.commerceCard.promotion.learnmore']}}
产品信息
PA5-111039
种属反应
宿主/亚型
分类
类型
抗原
偶联物
形式
浓度
规格
纯化类型
保存液
内含物
保存条件
运输条件
RRID
产品详细信息
Immunogen sequence: VQTLTLGQVA AGGAFTSTPV SLSTGQLPNL QTVTVNSIDS AGIQLHPGEN ADSPADIRIK EEEPDPEEWQ LSGDSTLNTN DLTHLRVQVV DEEGDQQ
Highest antigen sequence indentity to the following orthologs: Mouse - 98%, Rat - 98%.
靶标信息
This gene belongs to a family of Sp1 related genes that encode transcription factors that regulate transcription by binding to consensus GC- and GT-box regulatory elements in target genes. This protein contains a zinc finger DNA-binding domain and several transactivation domains, and has been reported to function as a bifunctional transcription factor that either stimulates or represses the transcription of numerous genes. Transcript variants encoding different isoforms have been described for this gene, and one has been reported to initiate translation from a non-AUG (AUA) start codon. Additional isoforms, resulting from the use of alternate downstream translation initiation sites, have also been noted. A related pseudogene has been identified on chromosome 13.
仅用于科研。不用于诊断过程。未经明确授权不得转售。
篇参考文献 (0)
生物信息学
蛋白别名: alternatively spliced; DKFZp686O1631; GC-binding transcription factor Sp3; specificity protein 3; SPR-1; SPR-2; SPR1; Transcription factor Sp3; transcription factor; Sp3; unnamed protein product
基因别名: SP3; SPR2
UniProt ID: (Human) Q02447
Entrez Gene ID: (Human) 6670